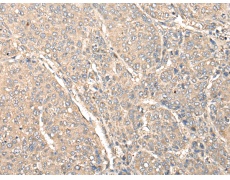
一抗

別 名: NEF5, NF-66, TXBP-1
相關類別: 一抗
抗 原: INA
|
Background: |
Neurofilaments are type IV intermediate filament heteropolymers composed of light, medium, and heavy chains. Neurofilaments comprise the axoskeleton and they functionally maintain the neuronal caliber. They may also play a role in intracellular transport to axons and dendrites. This gene is a member of the intermediate filament family and is involved in the morphogenesis of neurons. |
|
Applications: |
ELISA, IHC |
|
Name of antibody: |
INA |
|
Immunogen: |
Synthetic peptide of human INA |
|
Full name: |
Internexin neuronal intermediate filament protein, alpha |
|
Synonyms: |
NEF5, NF-66, TXBP-1 |
|
SwissProt: |
Q16352 |
|
ELISA Recommended dilution: |
1000-5000 |
|
IHC positive control: |
Human lung cancer and Human renal cancer |
|
IHC Recommend dilution: |
25-100 |



 購物車
購物車 幫助
幫助
 021-54845833/15800441009
021-54845833/15800441009